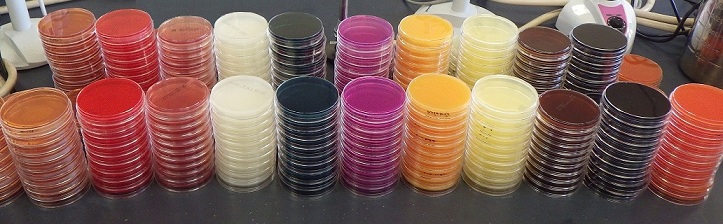
���V�|�n

食品衛生/食中毒
細菌性食中毒
細菌性食中毒の検査について
福岡県保健環境研究所では、食中毒(疑い)事例が起きた際に、原因物質を特定する業務を行っています。 食中毒の原因を特定し、その原因を取り除くことで、さらに被害が広がることを防ぐことができます。 食中毒の原因は様々ですが、病理細菌課では、主に細菌・寄生虫による食中毒の検査を行っています。
細菌性食中毒の原因について
細菌性食中毒は、「食中毒を起こす細菌」が付着した食品・飲料水などを飲食することで起こります。 食品に細菌が付着する原因は主に、①調理による汚染、②食材(料理の材料)からの汚染などが考えられます。 1つめの「調理による汚染」は、汚い調理器具・手指の細菌が食品に入ってしまうことで起こります。 2つめの「食材の汚染」は、食品の加熱調理不足(十分に火が通っていないこと)や洗浄不足などで、 元から食材に付着していた細菌を十分に取り除くことが出来なかった事により起こります。
厚生労働省の食中毒統計によると、食中毒事件の半分程度が細菌によるものとされています。 原因となる細菌には、カンピロバクター、サルモネラ、黄色ブドウ球菌、腸管出血性大腸菌、ウェルシュ菌、腸炎ビブリオ、セレウス菌などが挙げられます。

※ 食中毒統計資料(厚生労働省)(http://www.mhlw.go.jp/stf/seisakunitsuite/bunya/kenkou_iryou/shokuhin/syokuchu/04.html)を基に作成
症状と潜伏期間
症状や潜伏期間(食品を食べてから症状がでるまでの期間)は、原因となる細菌によって様々です。 細菌による食中毒では消化器症状(下痢、嘔吐、腹痛など)が中心ですが、発熱、発疹、麻痺、意識障害といった症状が現れることもあります。 潜伏期間は、30分程度から1週間以上と様々です。
寄生虫による食中毒
最近、ヒラメからはクドア・セプテンプンクタータ、馬肉からはザルコシスティス・フェアリーという食中毒を起こす寄生虫が発見されました。 当課では細菌の他に、これらの寄生虫の検査を行っています。
食中毒を防止するために
私達は、このような細菌・寄生虫の検査業務を通じて、食中毒の原因となった飲食店の指導や、原因食品を取り除くことで、県民の皆様の「食の安全」の確保に貢献しています。
一方で、食中毒の多くは、家庭で起きています。家庭で細菌性食中毒を予防するためは、
「食中毒予防の3原則」を守ることが大切です。
- つけない ・・・・ 手をよく洗う。調理器具をよく洗う。
- 増やさない ・・・・ 食品・食材はしっかり低温で保管する。
- やっつける ・・・・ ほとんどの菌は加熱処理で死ぬので、調理する際に十分に火を通すことが大事。
食中毒の原因と、その予防法を正しく知り、予防に努めましょう